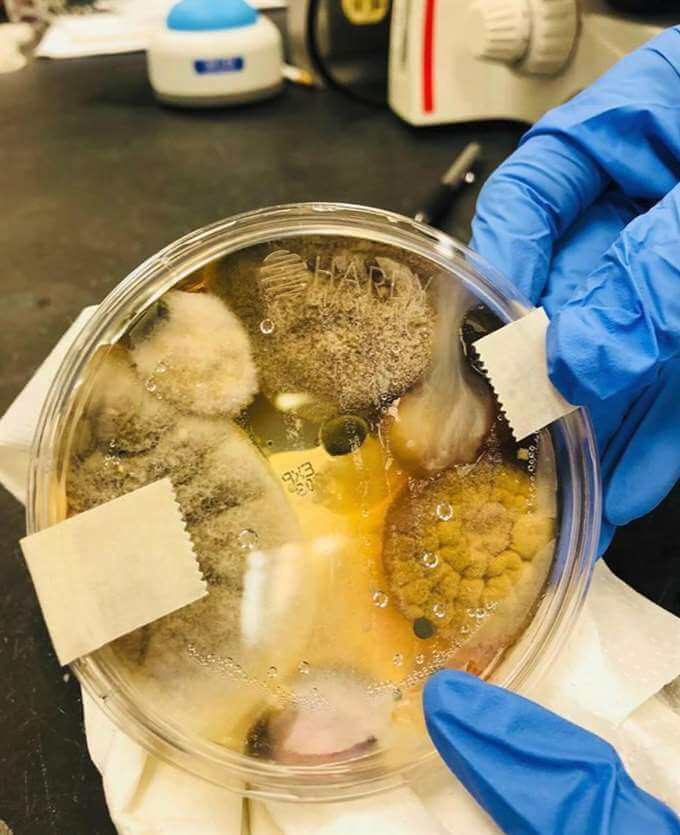

Nichole gjorde ett experiment på offentliga toaletter. Resultatet? Det här är äckligt!
Nichole har under en längre tid gått runt och funderat på sanningen gällande handtorkar på allmänna toaletter. Hon har nu gjort ett experiment om det som hon sedan publicerade på sociala medier.
Resultatet som hon fick i sitt experiment har väckt starka reaktioner bland människorna. En chockerad användare skriver: – Jag har använt så många handtorkar men nu vet jag sanningen.
Handtorkar som blåser luft är kanske inte så himla fräscha som du tror. Om vi ska tro vissa experter så ska det vara det mest hygieniska alternativet som finns medan andra säger att det är en bakteriehärd.
Nichole Ward hade funderat på hur det egentligen låg till med detta och bestämde sig för att ta reda på sanningen för ett par veckor senare. Resultatet som hennes experiment visade har nu chockat tusentals människor, rapporterar nyhetssajten The Sun.

Utförde testet på en allmän toalett
För att få reda på sanningen så tog Nichole, som kommer från Kalifornien i USA, med sig en plastskål som används på laboratorier, en så kallad petriskål, med sig till en allmän toalett.
I cirka tre minuter så höll hon denna under en handtork och väntade sedan i 48 timmar. Det var efter det som hon gjorde det skrämmande resultatet.

Under de timmarna så odlades mikroorganismerna i petriskålen.
När Nichole såg detta skrämmande resultat så bestämde hon sig för att ta en bild och dela med sig av det hon just upptäckt i sociala medier – tillsammans med en varning till allmänheten.
”Du tror att dina händer är rena”
– Okej hörni, är ni redo att bli överväldigade? Skriver Nichole i sitt inlägg och fortsätter:
– Det här är vad som odlades i en petriskål på ett par dagar. TORKA ALDRIG era händer under en handtork igen. Det här är bakterierna som du vrider runt i dina händer samtidigt som du tror att du går ut med rena händer.
Bilden talar för sig själv:
Starka reaktioner
Det är oklart om Nichole har någon bakgrund som forskare. Men oavsett vad så har bilden som hon delade med sig från sitt experiment väckt starka reaktioner som har fått många människor att reagera. Många människor som sett bilden kommer aldrig använda handtorkar igen.
– Så himla äckligt. Jag kommer aldrig att använda en sådan igen, skriver en användare.
– Jag har använt så många handtorkar men nu vet jag sanningen, skriver en annan.
Bilden som Nichole Ward laddade upp på Facebook har fått över 575 000 delningar.
Efter att ha sett denna bild kommer du troligtvis, precis som jag, att inte använda handtorkar på offentliga toaletter längre.
Hjälp till att varna andra genom att dela denna artikel vidare.
I videoklippet här under kan du se en video som kan vara en förklaring:
Glöm inte bort att dela detta med dina vänner!
